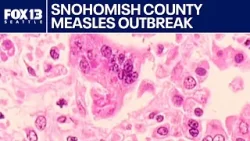
Snohomish County measles outbreak grows to six cases, health officials say | FOX 13 Seattle Snohomish County measles outbreak grows to six cases, health officials say | FOX 13 Seattle

Q13 - FOX 13 Seattle online - Televizija uživo

Q13 - FOX 13 Seattle Uživo prijenos
Budite u tijeku s Q13 - FOX 13 Seattle! Pratite najnovije vijesti, vremensku prognozu i zabavu putem njihovog prijenosa uživo. Gledajte televiziju na mreži za najnovije vijesti i lokalne novosti u Seattleu i šire.
U dinamičnom krajoliku televizijskog emitiranja, Q13 - FOX 13 Seattle sebi je urezao nišu kao glavni izvor za vijesti, vremensku prognozu i zanimljiv zabavni sadržaj. Emitirajući u živopisnom gradu Seattleu i njegovim okolnim područjima, ovaj cijenjeni kanal postao je poznato ime, pružajući informacije u stvarnom vremenu i zadivljujuće priče koje odjekuju među raznolikom publikom.
S pojavom tehnologije i promjenom preferencija gledatelja, koncept televizije evoluirao je izvan tradicionalnih kabelskih mreža. Q13 prepoznaje ovu promjenu i nudi značajku besprijekornog prijenosa uživo, omogućujući gledateljima da gledaju televiziju online kada im odgovara. Bilo da ste kod kuće, na poslu ili u pokretu, Q13 osigurava da ste povezani s pulsom grada i svijeta izvan njega.
Vijesti su u središtu programa Q13, a kanal se ponosi pružanjem točnih i najnovijih informacija svojim gledateljima. Od najnovijih vijesti koje zahtijevaju trenutnu pozornost do detaljnih istraživačkih izvješća koja bacaju svjetlo na kritična pitanja, Q13 svoju publiku informira, osnažuje i angažira. Njegov tim iskusnih novinara i izvjestitelja neumorno radi na pokrivanju lokalnih događaja, političkih događaja, društvenih pitanja i globalnih događaja, pružajući sveobuhvatan pogled na zbivanja u svijetu.
Osim što je pouzdan izvor vijesti, Q13 služi i kao meteorološka agencija za pacifičku sjeverozapadnu regiju. S raznolikom klimom ovog područja i jedinstvenim vremenskim obrascima, meteorolozi Q13 igraju ključnu ulogu u pružanju točnih prognoza i ažuriranja vremenskih prilika. Bilo da se radi o kišnoj oluji, snijegu ili sunčanom danu, Q13 osigurava da su njegovi gledatelji spremni i opremljeni za suočavanje s elementima.
Osim vijesti i vremena, Q13 - FOX 13 Seattle shvaća važnost zabave u životima svojih gledatelja. Kanal priprema širok raspon programa koji zadovoljavaju različite interese i dobne skupine. Od zadivljujućih drama i uzbudljivih reality showova do dirljivih priča o ljudima i sadržaja prikladnog za obitelj, Q13 nudi dobro zaokruženo iskustvo gledanja koje publiku zabavlja i zaokuplja.
Kao kanal duboko ukorijenjen u zajednicu Seattlea, Q13 ponosi se pojačavanjem različitih glasova i predstavljanjem bogate kulturne tapiserije grada. Aktivno surađuje s lokalnim organizacijama, poduzećima i čelnicima zajednice na promicanju događaja, inicijativa i projekata koji pozitivno pridonose rastu i razvoju regije.
Štoviše, Q13 - FOX 13 Seattle vjeruje u transparentnost i odgovornost u novinarstvu. Potiče građanski angažman i angažman zajednice pružajući platformu za otvoreni dijalog i diskurs. Kanal aktivno traži povratne informacije od svojih gledatelja, priznajući njihovu ulogu aktivnih sudionika u oblikovanju njegovog sadržaja i smjera.
Q13 - FOX 13 Seattle i dalje je pouzdan i cijenjen televizijski kanal koji ostaje na čelu dostavljanja vijesti, ažuriranja vremenske prognoze i zabave stanovnicima Seattlea i šire. Kroz značajku prijenosa uživo, kanal je prihvatio tehnološki napredak, osiguravajući svojim gledateljima pristup sadržaju kad god i gdje god žele. Predanost Q13 pružanju činjeničnih informacija, angažiranju programa i inicijativama usmjerenim na zajednicu ponovno potvrđuje svoj status cijenjene medijske organizacije koja osnažuje svoju publiku i potiče osjećaj povezanosti unutar zajednice kojoj služi. Kako se medijsko okruženje nastavlja razvijati, Q13 - FOX 13 Seattle stoji visoko kao svjetionik autentičnosti, integriteta i nepokolebljive predanosti svojim gledateljima i pričama koje su im najvažnije.


